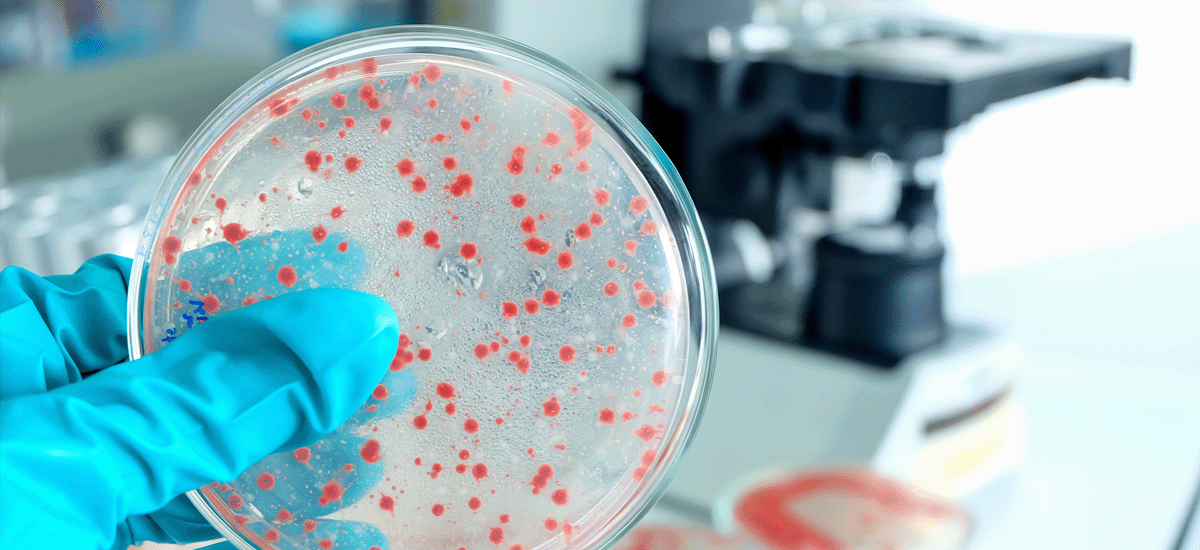

霍尼韋爾全球安防知名品牌
霍尼韋爾全球研發(fā),本土化生產(chǎn)銷(xiāo)售和服務(wù)。
華瑞voc氣體檢測(cè)儀,加拿大BW,BW Technologies by Honeywell,斯博瑞安,梅思安均隸屬霍尼集團(tuán);
暢銷(xiāo)全球150+國(guó)家。
標(biāo)定校準(zhǔn) 檢測(cè)維修 壓縮空氣檢測(cè) 潔凈室檢測(cè) 設(shè)備3Q驗(yàn)證 儀器租賃
壓縮空氣檢測(cè)儀 露點(diǎn)儀|露點(diǎn)變送器 壓縮空氣檢測(cè)管 微量氧分析儀 醫(yī)用氧檢測(cè)儀
便攜式氣體檢測(cè)儀 固定式氣體檢測(cè)儀 單一氣體檢測(cè)儀 復(fù)合氣體檢測(cè)儀 四合一氣體檢測(cè)儀 VOC氣體檢測(cè)儀 可燃?xì)怏w檢測(cè)儀 有毒氣體檢測(cè)儀 氣體泄漏檢測(cè)儀 氣體檢測(cè)管 標(biāo)準(zhǔn)氣體|瓶閥
上泰PH計(jì) 電導(dǎo)率儀 濁度儀濁度計(jì) 余氯檢測(cè)儀 溶解氧測(cè)定儀 總磷測(cè)定儀 氨氮測(cè)定儀 COD檢測(cè)儀 水質(zhì)分光度計(jì) BOD測(cè)定儀 消解器 試劑耗材
口罩面罩呼吸器 MVE液氮罐 SKC采樣器 TSI流量計(jì)
離心機(jī) 混勻器 攪拌器 分散機(jī) 移液槍移液器 水龍頭洗眼器
十二年 相伴下一輪
可選品牌齊全,德?tīng)柛馜rager,霍尼韋爾honeywell,華瑞RAE,加拿大BW,梅思安,斯博瑞安,英思科,理研,新宇宙,盟蒲安等。
支持檢測(cè)分析水質(zhì)PH值電導(dǎo)率,濁度,余氯溶解氧,氨氮總磷,合作品牌連華科技,梅特勒,哈希,上泰,哈納,水質(zhì)檢測(cè)儀準(zhǔn)確可靠。
實(shí)驗(yàn)室設(shè)備種類(lèi)齊全,包括稱(chēng)重量具,清洗消毒設(shè)備,制樣消解設(shè)備,分離純化設(shè)備,混合分散設(shè)備,恒溫加熱干燥設(shè)備。
德?tīng)柛馎erotest用于檢測(cè)氣瓶或壓縮氣體如壓縮空氣質(zhì)量,德國(guó)原裝進(jìn)口,現(xiàn)貨供應(yīng),支持提供上門(mén)培訓(xùn)服務(wù)。

根據(jù)潔凈室檢測(cè)項(xiàng)目提供有針對(duì)性的檢測(cè)設(shè)備,潔凈度檢測(cè)使用的激光塵埃粒子計(jì)數(shù)器,無(wú)菌驗(yàn)證使用浮游菌采樣器。
壓縮空氣系統(tǒng)需經(jīng)過(guò)驗(yàn)證,以證明系統(tǒng)符合生產(chǎn)要求并通過(guò)GMP的認(rèn)證檢查。
服務(wù)熱線(xiàn) 021-31001568
聯(lián)系我們世界500強(qiáng)企業(yè)合作伙伴!

霍尼韋爾全球研發(fā),本土化生產(chǎn)銷(xiāo)售和服務(wù)。
華瑞voc氣體檢測(cè)儀,加拿大BW,BW Technologies by Honeywell,斯博瑞安,梅思安均隸屬霍尼集團(tuán);
暢銷(xiāo)全球150+國(guó)家。
京工做高性?xún)r(jià)比儀器儀表導(dǎo)購(gòu)平臺(tái),價(jià)格透明,規(guī)范高效。
滿(mǎn)足您對(duì)精密儀器儀表需求,保證質(zhì)量的同時(shí),為您節(jié)約綜合成本。

每個(gè)銷(xiāo)售背后都有資深技術(shù)團(tuán)隊(duì)在做支持;京工注重技術(shù)團(tuán)隊(duì)的研發(fā)投入。
銷(xiāo)售服務(wù)一對(duì)一,保證客戶(hù)無(wú)需重復(fù)溝通,協(xié)助客戶(hù)選型,專(zhuān)注貨物交付。

精選行業(yè)優(yōu)質(zhì)供應(yīng)商,每臺(tái)設(shè)備可追溯。
開(kāi)箱檢驗(yàn),極限測(cè)試。
每一臺(tái)儀器都經(jīng)歷嚴(yán)格測(cè)試,讓您安全放心使用。

耗材易損件配置齊全。
全球質(zhì)保,售后無(wú)憂(yōu),維修效率高;
提供設(shè)備維修校準(zhǔn)服務(wù),氣體檢測(cè)儀單天完成,疑難問(wèn)題3天之內(nèi)維修完畢。

Class I, Div. 1, Gr. A, B, C, D
IECEx: Ga Ex ia IIC T4
ATEX: II 1 G Ga Ex ia IIC T4
公司提供在售儀器儀表各種問(wèn)題免費(fèi)指導(dǎo),歡迎客戶(hù)就設(shè)備使用問(wèn)題,技術(shù)問(wèn)題在線(xiàn)咨詢(xún)。

壓縮空氣質(zhì)量不達(dá)標(biāo)會(huì)對(duì)電子行業(yè)的產(chǎn)品質(zhì)量、生產(chǎn)效率和生產(chǎn)成本等方面產(chǎn)生諸多不良影響。壓縮空氣中的導(dǎo)電顆?;蛩街陔娮釉砻?,可能使相鄰線(xiàn)路或引腳之間的絕緣...

鵬達(dá)精密包裝材料(上海)有限公司是一家以從事橡膠和塑料制品業(yè)為主的企業(yè),生產(chǎn)、加工熱塑產(chǎn)品,是一家外資公司,十年前與上海京工第一次合作后,我們保持了十年之久的合作關(guān)系,壓縮空氣的質(zhì)量不僅取決于空氣的清潔程度,還取決于空氣干燥程度。...

中國(guó)藥典《醫(yī)用氧標(biāo)準(zhǔn)》公布標(biāo)準(zhǔn),方法和實(shí)施時(shí)間后,老師們紛紛來(lái)電咨詢(xún)醫(yī)用氧檢測(cè)管的量程和貨號(hào),以及使用方法的確認(rèn)。醫(yī)用氧檢測(cè)管的量程,精度范圍與德?tīng)柛駲z測(cè)管完全一致:且有獨(dú)特簡(jiǎn)單的采樣設(shè)備。...

即便接種了疫苗,還是有可能被感染以及帶著病毒再傳給別人,因此打過(guò)疫苗也要戴上口罩,注意防范!符合標(biāo)準(zhǔn)的KN95口罩從材料上對(duì)德?tīng)査?,奧密克戎???????病毒有至少95%以上的過(guò)濾效率。...
安心陪伴每一天,每一年
石油、天然氣管道泄漏可能導(dǎo)致火災(zāi)、爆炸等嚴(yán)重事故,對(duì)周邊環(huán)境和人員造成巨大威脅。通過(guò)無(wú)人機(jī)搭載激光可燃?xì)鈾z測(cè)儀,可用于監(jiān)測(cè)沿...
2025-01-09壓縮空氣必須符合GMP制藥用潔凈壓縮空氣的標(biāo)準(zhǔn),以保證藥品質(zhì)量符合GMP標(biāo)準(zhǔn),食品加工行業(yè),壓縮空氣必須符合食品安全標(biāo)準(zhǔn),以確保食品的...
2024-12-022023年10月12日 - 德國(guó)CS INSTRUMENTS 今天宣布推出了其創(chuàng)新產(chǎn)品 OIL CHECK 500,這是一款專(zhuān)為長(zhǎng)期高精度測(cè)量壓縮空氣中汽化殘油含...
2023-10-18當(dāng)電子行業(yè)懷疑壓縮空氣系統(tǒng)不合格時(shí),迅速采取措施至關(guān)重要。首先,停止使用疑似不合格的壓縮空氣,避免可能的產(chǎn)品損壞。進(jìn)行壓縮空氣...
2023-10-13山東五分局堅(jiān)持問(wèn)題導(dǎo)向,增強(qiáng)風(fēng)險(xiǎn)意識(shí),認(rèn)真梳理去年2022年藥品生產(chǎn)環(huán)節(jié)風(fēng)險(xiǎn)因素,形成了風(fēng)險(xiǎn)評(píng)估報(bào)告,促進(jìn)藥品生產(chǎn)科學(xué)監(jiān)管、精準(zhǔn)監(jiān)管...
2023-04-032023年3月23日,這是我們第十四次參加德?tīng)柛窠?jīng)銷(xiāo)商大會(huì),每年都能看到新的產(chǎn)品,學(xué)習(xí)新的產(chǎn)品知識(shí),了解新動(dòng)態(tài),今年德?tīng)柛裉岢龉糙A(yíng)理念,并...
2023-03-23藥企客戶(hù)GMP認(rèn)證需要使用德?tīng)柛駢嚎s空氣質(zhì)量檢測(cè)儀,我司為藥企客戶(hù)的開(kāi)通視頻培訓(xùn)直播服務(wù),可根據(jù)客戶(hù)實(shí)際檢測(cè)內(nèi)容重點(diǎn)剖析原因,針...
2023-03-14春節(jié)前夕我司工程師奔赴江西礦業(yè),做德?tīng)柛駳怏w檢測(cè)儀年度標(biāo)定校準(zhǔn)工作,確保有毒氣體放映到靈敏度和準(zhǔn)確度,為工廠(chǎng)安全把關(guān)。煤礦用氣...
2023-01-17德?tīng)柛駭y手化里有話(huà)開(kāi)展了“石油化工與制藥行業(yè)之受限空間作業(yè)技術(shù)研討會(huì)”,特別邀請(qǐng)全國(guó)安標(biāo)委化學(xué)品安全分標(biāo)委秘書(shū)長(zhǎng)太文哲老師...
2022-11-03PSS AirBoss自給式空氣呼吸器和HPS SafeGuard消防頭盔整個(gè)研究、開(kāi)發(fā)和設(shè)計(jì)過(guò)程均與消防、工業(yè)、醫(yī)療和教育組織一起進(jìn)行,以確保我...
2022-08-16露點(diǎn)與 PPM 的換算,計(jì)算思路:根據(jù)露點(diǎn)溫度可以通過(guò)查找水蒸氣飽和蒸氣壓表或利用相關(guān)的經(jīng)驗(yàn)公式,得到對(duì)應(yīng)溫度下的飽和蒸氣壓,再結(jié)合...
2025-01-03德國(guó)CS儀表即CS Instruments,是德國(guó)工業(yè)氣體檢測(cè)儀器品牌,所屬公司是CS Instruments GmbH & Co. KG由Christian Schuldt和Wolfgang ...
2024-08-01在沒(méi)有壓縮空氣質(zhì)量標(biāo)準(zhǔn)和等級(jí)的情況下,對(duì)壓縮空氣進(jìn)行檢測(cè)和評(píng)估將變得困難和模糊。標(biāo)準(zhǔn)和等級(jí)的制定是為了確保壓縮空氣的質(zhì)量符...
2024-01-29德?tīng)柛馲-AM2500氣體檢測(cè)儀是一款高性能的氣體檢測(cè)設(shè)備,廣泛應(yīng)用于工業(yè)、礦山、化工等領(lǐng)域,用于監(jiān)測(cè)和檢測(cè)空氣中的有害氣體。為了確...
2023-10-26德?tīng)柛馬TO可燃?xì)釲EL在線(xiàn)監(jiān)測(cè)采樣探頭通過(guò)接口連接工藝管道上,通過(guò)采樣泵把工藝廢氣抽入采樣單元進(jìn)氣口,經(jīng)過(guò)帶冷凝功能的水塵過(guò)濾器...
2023-06-20英國(guó)離子便攜式VOC 氣體檢測(cè)儀擁有革命性的PID 技術(shù),提供最廣闊的檢測(cè)量程和最好的軟件功能,可直接即開(kāi)即用!...
2023-05-24一、中國(guó)醫(yī)療用氧法規(guī)演變與發(fā)展
1955年頒布《中國(guó)藥典》之時(shí),“氧氣”一詞便列入其中,但是對(duì)于醫(yī)療用氧一直沒(méi)有明確的...
醫(yī)用氧執(zhí)行標(biāo)準(zhǔn)主要包括哪些方面?氧氣純度:醫(yī)用氧氣純度要求在 99.5% 以上;
水分含量:醫(yī)用氧氣水分含量應(yīng)控制在50mg/m3以下;一氧化碳...
使用便攜式BW氣體檢測(cè)儀優(yōu)點(diǎn)多,使用簡(jiǎn)單,但在使用BW氣體檢測(cè)儀時(shí),應(yīng)注意以下事項(xiàng):遵循嚴(yán)格的操作規(guī)程,使用之前檢查檢測(cè)儀完整性,充分預(yù)...
2023-03-21水塵過(guò)濾器售價(jià)低廉,購(gòu)置簡(jiǎn)單,使用方便,在泵吸式氣體檢測(cè)儀入口處安裝一個(gè),日??蓳趸覊m,如果不小心吸收了油水,透明材質(zhì),快速變色,在視覺(jué)...
2023-02-07
上海京工實(shí)業(yè)有限公司是國(guó)內(nèi)外專(zhuān)業(yè)的德?tīng)柛駢嚎s空氣質(zhì)量檢測(cè)儀,德?tīng)柛駳怏w檢測(cè)儀,霍尼韋爾Honywell/華瑞RAE,BW氣體檢測(cè)儀,水質(zhì)分析儀,上泰PH計(jì),自增壓液氮罐,四合一氣體檢測(cè)儀,沃辛頓液氮罐供應(yīng)商,客戶(hù)覆蓋制藥、化工、電子、汽車(chē)、噴涂、食品、環(huán)保、安防、空壓機(jī)等行業(yè)。上海京工實(shí)業(yè)有限公司以?xún)?yōu)質(zhì)產(chǎn)品、十年如一日的優(yōu)良服務(wù)贏(yíng)得客戶(hù)信賴(lài)。公司技術(shù)骨干來(lái)自制藥、環(huán)境、檢測(cè)、儀器儀表等行業(yè)的一線(xiàn)工程師,具有豐富的實(shí)踐經(jīng)驗(yàn),專(zhuān)注于可燃、有毒、有害氣體探測(cè)設(shè)備及相關(guān)安全防護(hù)用品的設(shè)計(jì)、開(kāi)發(fā)、生產(chǎn)、銷(xiāo)售和服務(wù),
聯(lián)系電話(huà)
微信掃一掃
